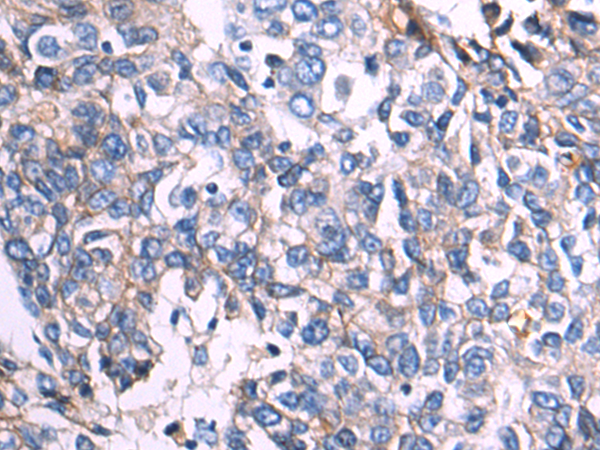

别名:UVO; CDHE; ECAD; LCAM; Arc-1; BCDS1; CD324应用:WB,IHC
反应种属:Human, Mouse, Rat
规格:50μl/100μl
| Description |
|---|
| This gene encodes a classical cadherin of the cadherin superfamily. Alternative splicing results in multiple transcript variants, at least one of which encodes a preproprotein that is proteolytically processed to generate the mature glycoprotein. This calcium-dependent cell-cell adhesion protein is comprised of five extracellular cadherin repeats, a transmembrane region and a highly conserved cytoplasmic tail. Mutations in this gene are correlated with gastric, breast, colorectal, thyroid and ovarian cancer. Loss of function of this gene is thought to contribute to cancer progression by increasing proliferation, invasion, and/or metastasis. The ectodomain of this protein mediates bacterial adhesion to mammalian cells and the cytoplasmic domain is required for internalization. This gene is present in a gene cluster with other members of the cadherin family on chromosome 16. |
| Specification | |
|---|---|
| Aliases | UVO; CDHE; ECAD; LCAM; Arc-1; BCDS1; CD324 |
| Swissprot | P12830 |
| WB Predicted band size | 97 kDa |
| Host/Isotype | Rabbit IgG |
| Storage | Store at 4°C short term. Aliquot and store at -20°C long term. Avoid freeze/thaw cycles. |
| Species Reactivity | Human, Mouse, Rat |
| Immunogen | Synthetic peptide of human CDH1 |
| Formulation | pH7.4 PBS, 0.05% NaN3, 40% Glycerol |
| Application | |
|---|---|
| WB | 1/1000-1/5000 |
| IHC | 1/50-1/200 |
| ELISA | 1/5000-1/10000 |
![]() |
Gel: 6%SDS-PAGE, Lysate: 40 μg, Lane 1-2: MCF7 cell, Mouse kidney tissue lysates, Primary antibody: P04135(CDH1 Antibody) at dilution 1/1000, Secondary antibody: Goat anti rabbit IgG at 1/5000 dilution, Exposure time: 5 seconds |
![]() |
The image is immunohistochemistry of paraffin-embedded Human liver cancer tissue using P04135(CDH1 Antibody) at dilution 1/55. (Original magnification: ×200) |
本公司的所有产品仅用于科学研究或者工业应用等非医疗目的,不可用于人类或动物的临床诊断或治疗,非药用,非食用。
暂无评论
本公司的所有产品仅用于科学研究或者工业应用等非医疗目的,不可用于人类或动物的临床诊断或治疗,非药用,非食用。
中文

发表回复